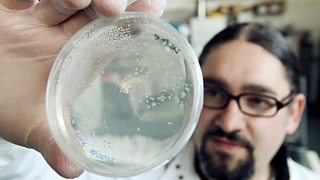

Main content
Corff CymruCyfres 2013Penodau Canllaw penodau
- Pob un
- Ar gael nawr (0)
- Nesaf (0)
![]()
Pennod 6
Rhai o'r pynciau dan sylw fydd heneiddio, meddyginiaeth bersonol a'r gorddefnydd o wrth...
![]()
Pennod 5
Geni ac etifeddiaeth fydd dan sylw gydag eitemau ar ofergoelion geni yng Nghymru a phra...
![]()
Pennod 4
Y system gylchrediad yw thema Corff Cymru'r wythnos hon. The circulatory system. What h...
![]()
Pennod 3
Y tro hwn cawn edrych ar ba effeithiau mae ein diet a'n hamgylchfyd yn eu cael ar ein c...
![]()
Pennod 2
Yr ymennydd sydd dan sylw yn y rhaglen hon ar Corff Cymru. The brain is the theme for t...
![]()
Pennod 1
Bydd Dr Anwen Rees yn darganfod mwy am y bobl gyntaf i fyw yng Nghymru. Dr Anwen Rees d...